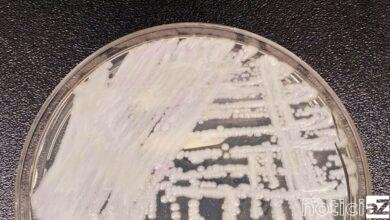
Fiocruz e Pasteur vão pesquisar sobre danos dos fungos no ser humano

FIOCRUZ
-

-
9 de novembro de 20240Consumo de álcool causa 12 mortes por hora no país, diz Fiocruz
-
19 de outubro de 20240Fiocruz oficializa pedido para produzir vacina contra dengue no Brasil
-
25 de abril de 20240Últimos dias de inscrições para 239 vagas no processo seletivo da Fiocruz
-
23 de março de 20240Fiocruz é candidata a Patrimônio Mundial pela Unesco
-
25 de junho de 20230Fiocruz e Pasteur vão pesquisar sobre danos dos fungos no ser humano
-
2 de abril de 20230Com nova “fábrica de Aedes aegypti”, Brasil ampliará combate a doenças
-
5 de fevereiro de 20230Maior parte do país mantém queda da Síndrome Respiratória Grave
-

-